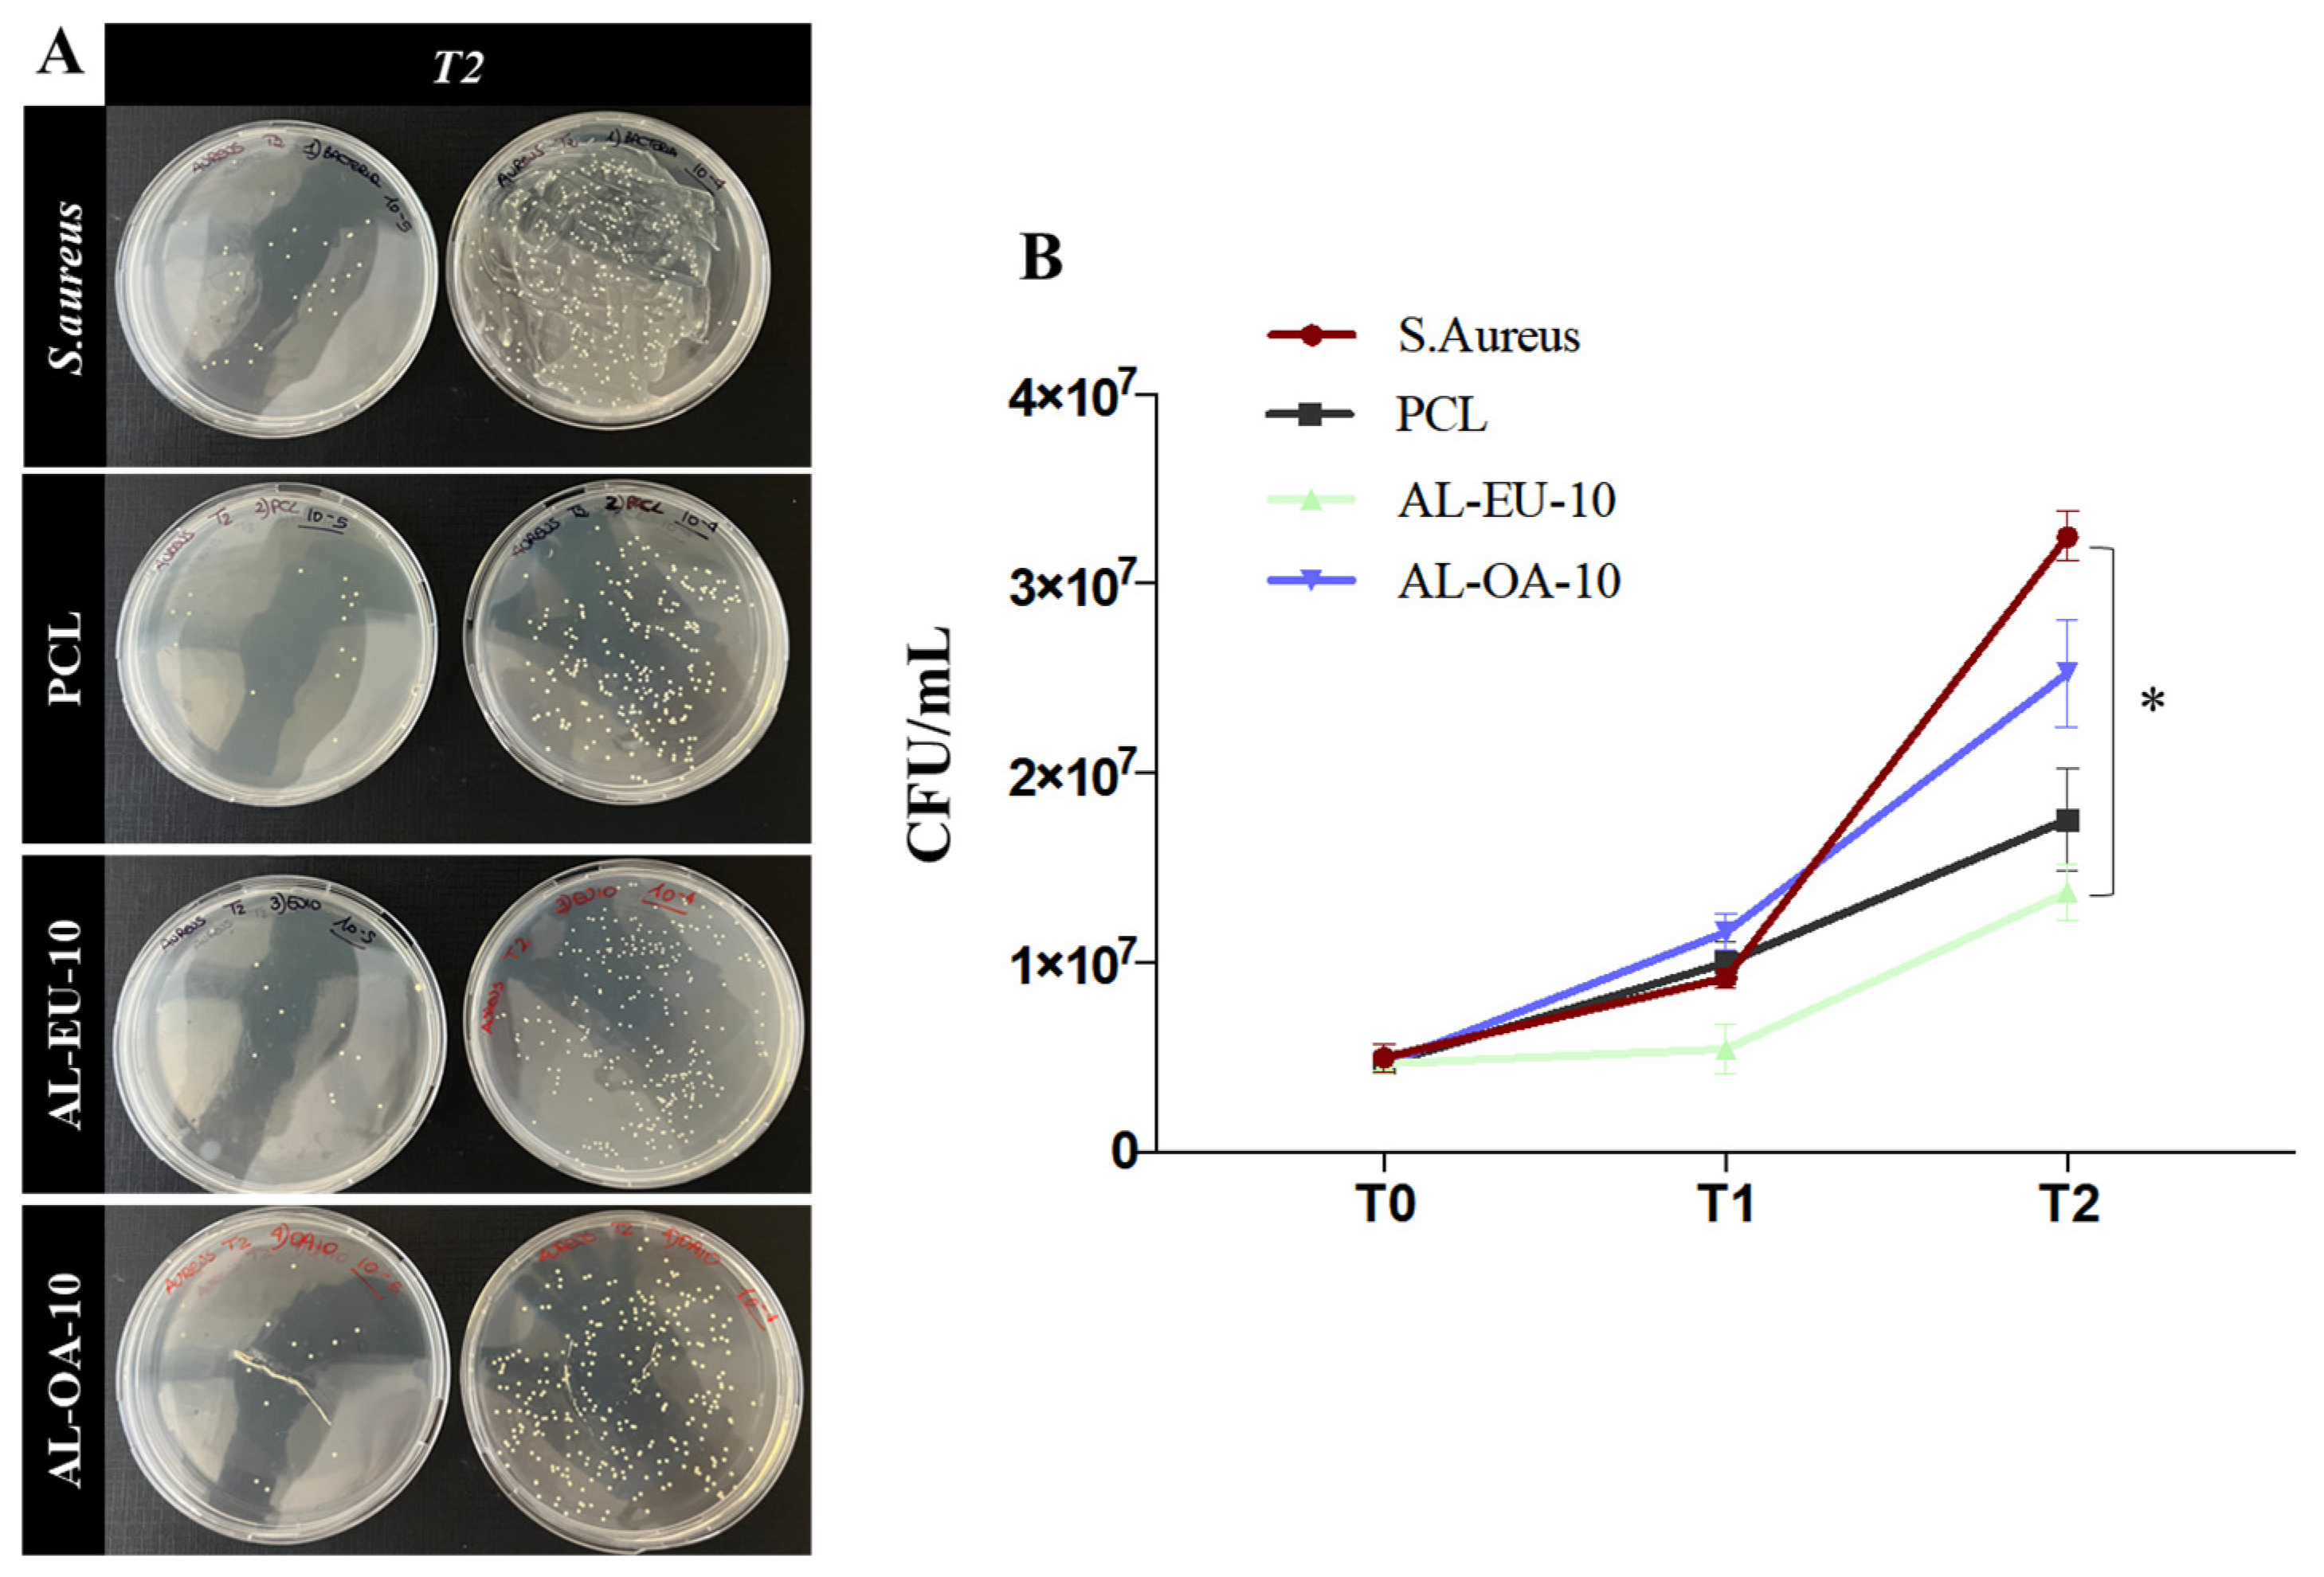
Polymers 16 00674 g011
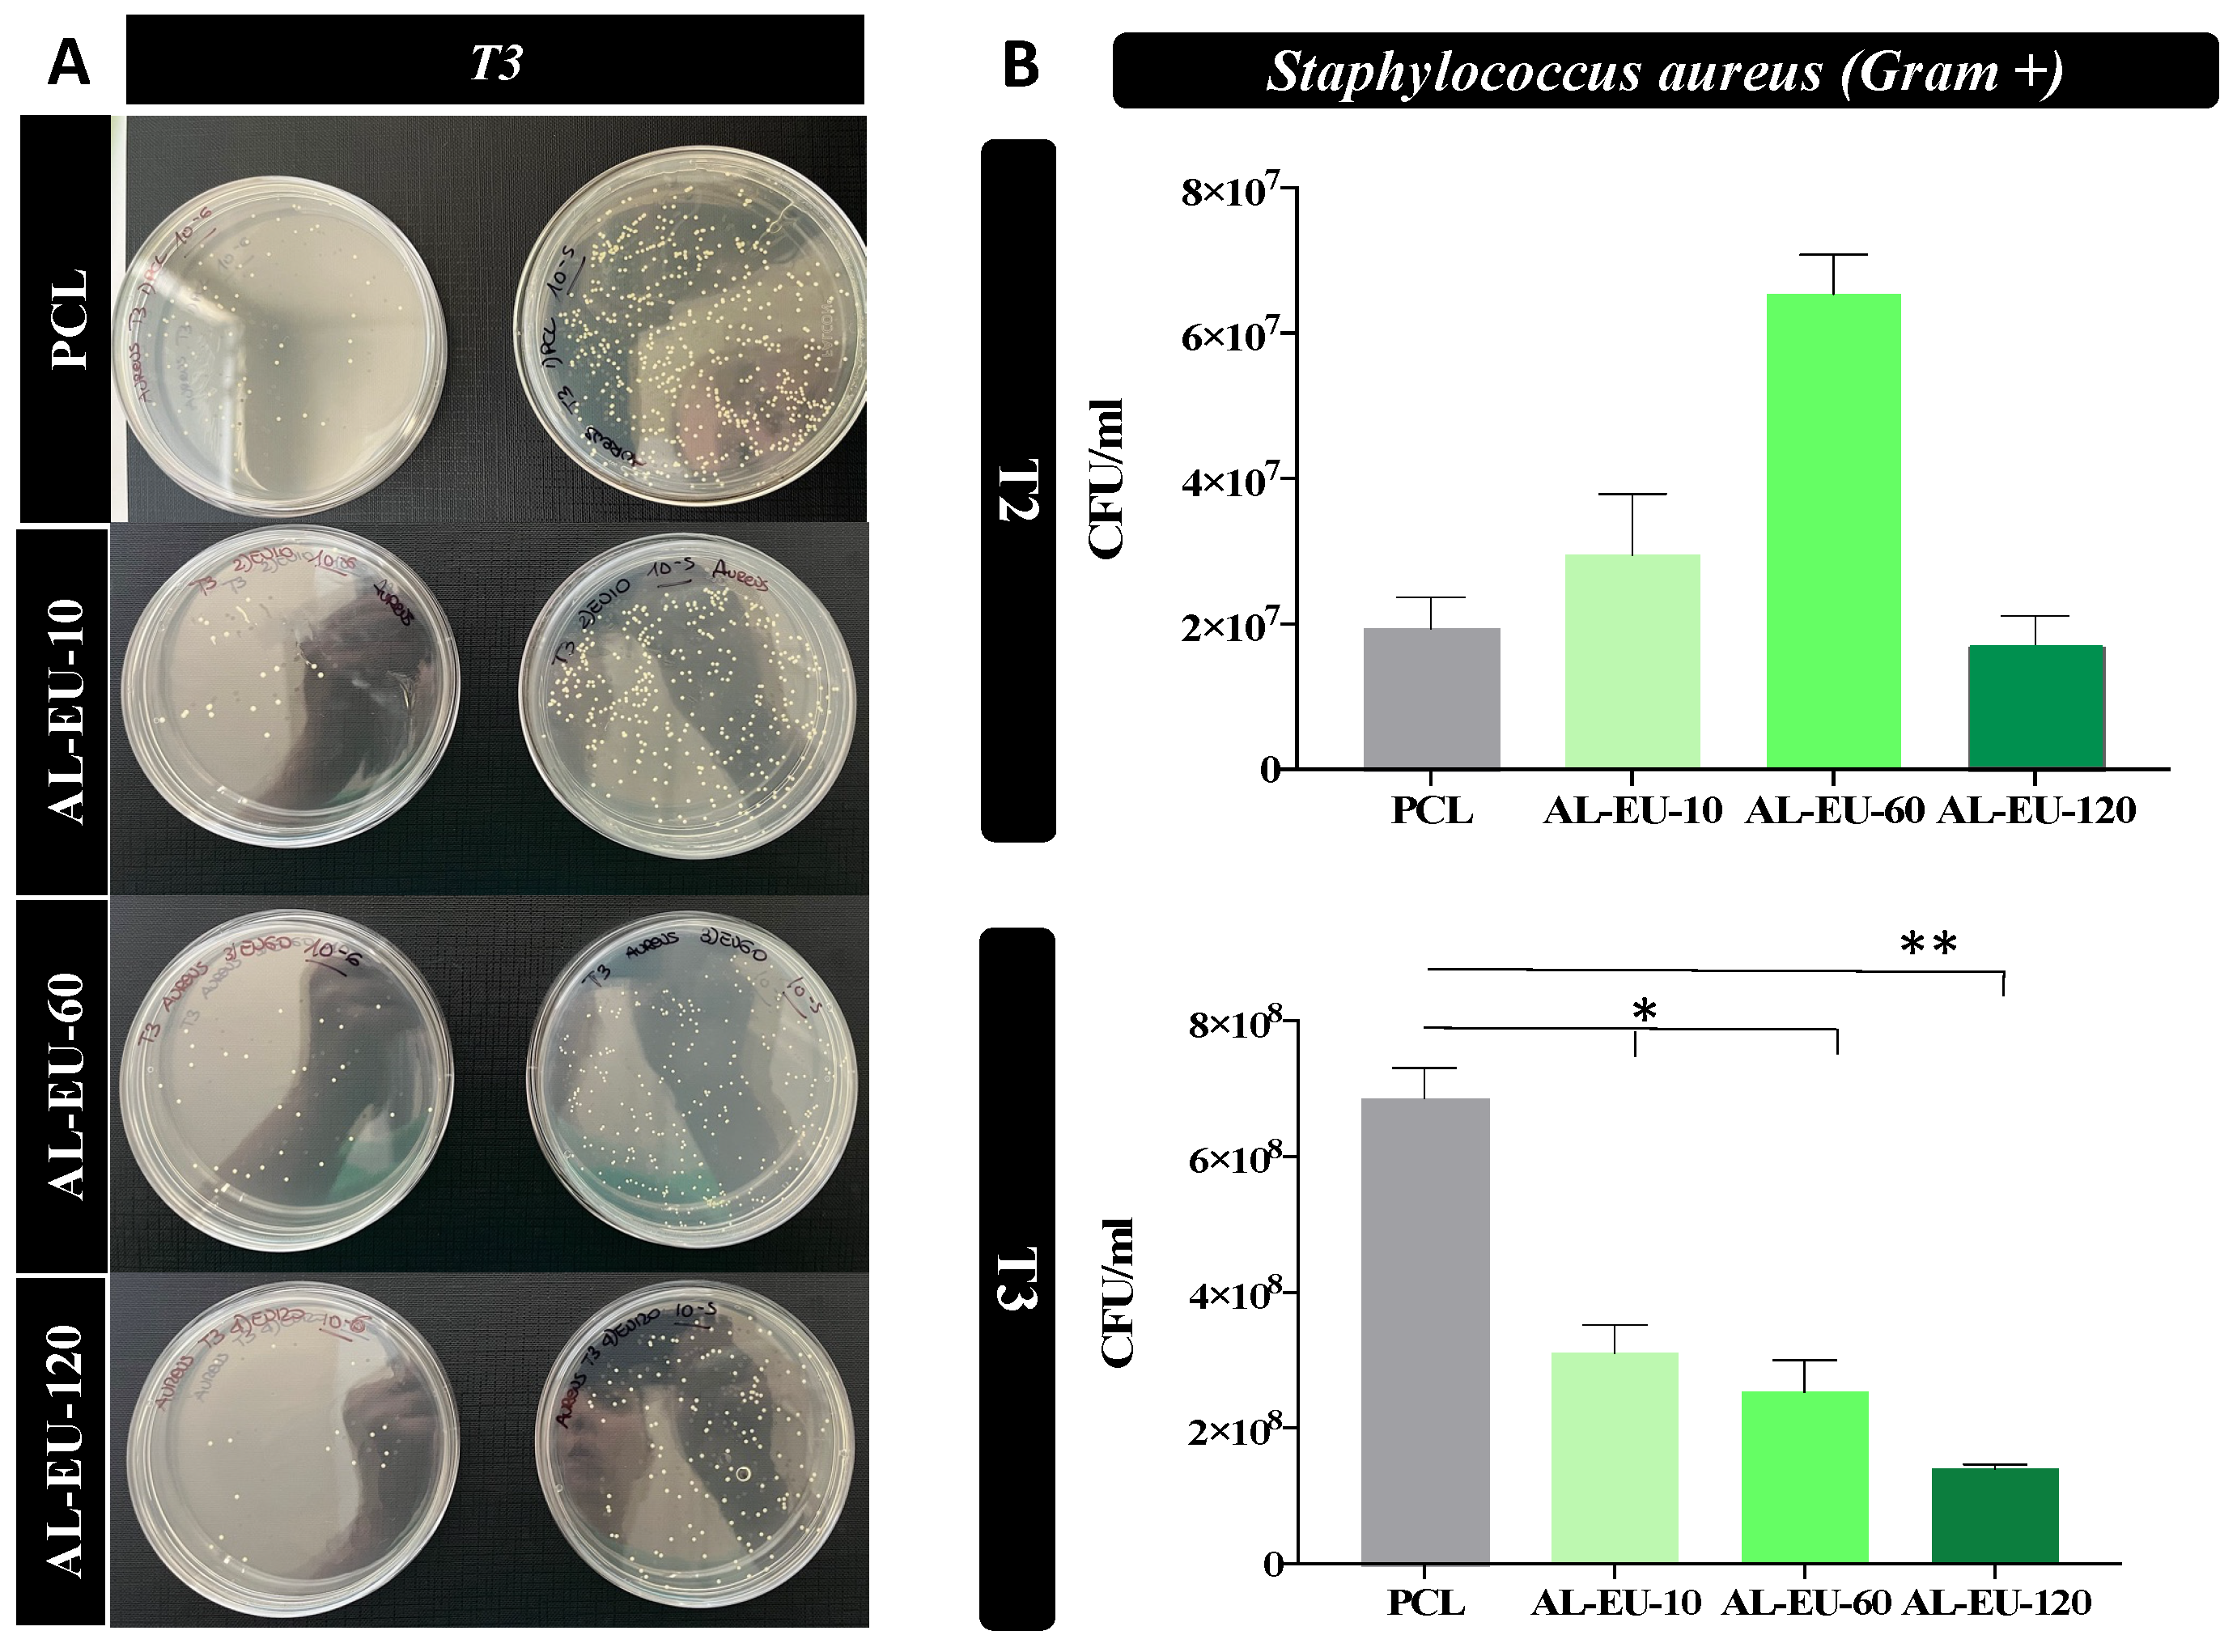
Polymers 16 00674 g012

1. Introduction
Water filtration using separation membranes is one of the methods employed for wastewater treatment, where such membranes act as a physical barrier, allowing the passage of water molecules while sieving molecules, microorganisms, and dissolved substances larger than a given cutoff [
1]. Polymeric membranes produced by electrospinning have shown significant potential for water filtration applications, garnering substantial interest over time due to their ability to create highly customizable materials with controlled porosity [
2]. In fact, electrospinning is an advanced manufacturing method of great interest in the filtration industry as it enables the production of either self-standing fibrous non-woven membranes or just coatings characterized by high porosity, open-pore microstructure, and a large surface area [
3]. The interconnected percolating pores within a fibrous electrospun layer are capable of enhancing filtration capacity [
4] and can be easily tailored in pore size and overall void fraction to modulate the filtration performance to achieve selective removal of target contaminants, such as particulates [
5], heavy metals [
6], oils and organic compounds [
7], and microbial agents like bacteria and viruses [
8]. Electrospinning is recognized as a very versatile technique for processing various polymers to create nanofiber-based membranes and coatings, but it can also be used in electrospray mode to produce emulsions or coatings made of particles made of micronized polymer [
9].
Several technological polymers are deployed in the electrospinning of filtering media. For example, polyacrylonitrile (PAN) is used for its excellent chemical, mechanical, and thermal properties [
10]. This polymer is often used in synergy with other materials; e.g., Perekh et al. [
11] produced electrospun PAN membranes incorporating silver nanoparticles to provide clean and drinkable water for underdeveloped countries. Polyvinylidene fluoride (PVDF) is another example of an interesting material with characteristics attractive for direct osmosis applications in seawater desalination [
12]. Polysulfone (PSU) is also commonly used in this field, both alone and in combination with other materials [
13]. For instance, PSU membranes coated with a layer of magnetite nanoparticles enabled the removal of model viruses (i.e., bacteriophage MS2) [
14], whereas adding a nanocoating of silver nanoparticles endowed PSU electrospun membranes with antibacterial properties [
15]. Yet, in the mainstream transition to a circular economy, the development of a new class of more sustainable electrospinning materials is becoming a key research objective.
In recent years, membranes made of poly(ε-caprolactone) (PCL) have been investigated as a relatively environmentally friendly option for water treatment applications [
16]. Despite being a synthetic polymer, PCL possesses desirable properties such as biodegradability and biocompatibility [
17]. These attributes are crucial for water treatment, as biodegradability allows for the degradation of PCL into products such as capronic acid, succinic acid, valeric acid, and butyric acid [
18]. by the action of microorganisms, making them environmentally friendly and suitable for disposal without causing harm to the environment [
19]. From the viewpoint of circular economy, this makes PCL a potential candidate to implement the demanufacturing of exhaust membranes and help address the end-of-life problems of current products. Biocompatibility is another important pre-requisite for safe exploitation, ensuring that the material is non-toxic to both humans and the environment [
20]. Furthermore, PCL is easily workable, offers excellent flexibility when combined with other polymers to modify its properties, and exhibits good solubility in a wide range of organic solvents commonly used in electrospinning processes [
21].
In the field of water filtration, reportedly, PCL was deployed for the fabrication of composite electrospun membranes with high performance when used in combination with cellulose nanofibrils (CNF) [
22]. In that case, the CNF enhanced the mechanical properties of the composite fibers and helped improve the filtration quality in terms of turbidity, conductivity, and the removal of metallic contaminants. This approach to membrane design is interesting as it yields a system that pairs a filtration performance tailorable by a functional additive (i.e., CNF in this example) to the intrinsic demanufacturing proneness of the PCL matrix. In another example, nanofibrous membranes made of chitosan and PCL delivered a composite architecture inheriting the antimicrobial properties of chitosan in combination with the advantageous characteristics of PCL [
23]. In another example, hybrid nanocomposite membranes of PCL/TiO
2 were investigated for the treatment of wastewater from the dairy industry, showing that such membranes could combine the hydrophobic properties and chlorine resistance of PCL with the antibacterial and anti-fouling properties associated with the hydrophilicity of titanium dioxide [
24]. Finally, our group also investigated several composite electrospun systems based on PCL, such as the PCL/Ag endowed with a Ag nanocoating of PCL fibers via magnetron sputtering [
25]. In conclusion, the design and manufacturing of advanced composite membranes obtained via electrospinning do represent a timely and rewarding exploration area.
In this paper, we investigate the combination of PCL with lignin, a new biomaterial that is attractive and is currently receiving significant attention. Lignin is, in fact, the second most abundant natural polymer in nature [
26] and represents a renewable and sustainable resource that can be harvested from several feedstocks of the wood industry. Lignin finds diverse applications across various industrial fields, including the coating industry for its UV protection capabilities [
27], the synthesis of therapeutic hydrogels [
28] for their antibacterial properties and biocompatibility, and as a precursor for high-value-added product manufacturing [
29]. Additionally, the abundance of functional groups makes lignin suitable for the production of flocculants, adsorbents, and dispersants [
30]. All these properties make lignins a worthy candidate to explore for water treatment applications.
Hereafter, we present a new 3-layered composite membrane consisting of a backing of filtering media, covered with a thick PCL layer inspired from our prior study [
25], and here functionalized by an innovative biocoating made of lignin via an electrospinning process driven in electrospray mode. We recall that electrospinning and electrospraying coexist on the same technological platform and just represent two regimes of the same electrohydrodynamic technique, leading to two different outcomes depending on the polymer solution being processed. Electrospinning and electrospraying represent cutting-edge methodologies for producing nanofibers and particles with controlled dimensions down to the nanoscale, using electric fields on the order of kilovolts per centimeter. These processes offer broad versatility in structure design, enabling manipulation of key parameters [
31] to achieve the desired morphology. These parameters can be classified into factors related to the solution [
32], operational parameters like applied electric field [
33] and working distance [
34,
35], and environmental factors such as temperature and relative humidity. In this article, we do not aim to delve into the theoretical chemical-physics aspects underlying these phenomena, as they are not the focus of the presented work. However, we aim to provide some basic information on the main practical differences between the employed techniques. As widely recognized, the nanofiber formation process involves a series of complex phenomena [
36], ranging from the initial formation of a straight jet from the solution, with the development of the Taylor cone, to the solidification of the polymeric material during its flight towards the collection substrate. The jet’s expulsion is influenced by various forces, including surface tension, viscoelastic force, repulsive forces, air drag force, and gravity [
37]. Furthermore, the driving force responsible for fiber generation is provided by the electrical potential difference between the injector and the collector.
In synergy with these aspects, the intrinsic properties of the polymeric solution play a crucial role. For example, each solution has a critical concentration value above which fiber formation is initiated, while lower concentrations allow for the production of monodisperse particles [
38]. The polymer molecular weight, closely related to the solution concentration value, determines the formation of fibers or dispersed particles. Based on the choice of the polymer’s molecular weight and the concentration of the solution, another important parameter arises, namely the final viscosity of the electrospun solution. In cases of low molecular weights and low-concentration solutions, as well as in the case reported here, a homogeneous spray of the dispersed polymer is achieved, while increasing viscosity pushes the process towards fiber production, as illustrated by McKee et al. [
39], who describe the correlation between solution rheology and the formation of electrospun fibers. Finally, electrical conductivity [
40] can interact with gravity and electrical forces, contributing to the formation of conical jets. Careful management of these parameters and solution properties is essential for achieving the desired results.
As there are many lignin grades, two different types of lignin are investigated and benchmarked here, namely acidolysis lignin (AL) from oak wood (AL-OA) and from eucalyptus wood (AL-EU) [
41]. Morphological, physical, and antibacterial studies were conducted on prototypical membranes, varying not only the type of lignin but also altering the electrospraying deposition time, with five different time points selected to monitor the evolution of the composite membrane properties and microstructure vs. deposition time. The main goal is to show that pure lignin can be processed by electrospraying to obtain a functional coating with thickness from the nanometer scale to the micrometer scale, but the scope of our research also covers aspects related to the possibility of varying the amount of deposited lignin (i.e., thickness or areal density of the coating) to modulate the functional properties. The latter aspect is relevant to adjusting the final filtration product to the specific requirements of a given engineering application.
2. Materials and Methods
2.1. Materials
PCL Capa 6800D from Perstorp (UK Limited, Warrington, UK), Acidolysis lignin from eucalypt (E. camaldulensis) and oak (Q. cerris) species, N,N-Dimethylformamide (DMF) from Supelco, Merck KGaA (Darmstadt, Germany), Chloroform (CHCl3) stabilized with 2-methyl-2-butene, provided from VWR chemicals (Radnor, PA, USA), Qualitative filter paper 600 from VWR International (Radnor, PA, USA), Ethanol absolute from Merck KGaA (Darmstadt, Germany), deionized water, 1 Primary Wound Dressing© (1PWD) (CE 0344)—Phytoceuticals, Zurich, Switzerland). Staphylococcus aureus (ATCC 29213) and Escherichia coli (ATCC 25922) were used, respectively, as representatives for Gram-positive and Gram-negative pathogens.
2.2. Preparation of Solutions and Fabrication of Membranes through Two Steps Electrospinning
Step 1: Supported PCL membranes were electrospun on a selected paper filter media (600, VWR International, Radnor, PA, USA) to produce a microfiltration membrane using industrial electrospinning equipment (Fluidnatek
® LE100, Bioinicia, Paterna, Spain) at NANOFABER S.r.l., equipped with a large stationary planar collector and an environmental control unit, enabling to keep temperature at 25 °C and relative humidity (RH) at 40% throughout manufacturing. The electrospinning of PCL was performed according to the recipe of a commercially available product, the PCL-NBARE ™ series (NANOFABER S.r.l., Rome, Italy), for the solution electrospinning of PCL granules in a mixture solvent of DMF and chloroform [
25]. The filtration paper covered with bare PCL represented the reference system throughout the study, referred to as “PCL” or “uncoated PCL” hereafter.
Step 2: For electrospraying the coating of lignin, two 5% (w,w) solutions of oak (AL-OA) and eucalypt lignin (AL-EU) in DMF were prepared. These two solutions were prepared using a thermostated bath at 60 °C and were magnetically stirred for two hours. The lignin solutions were subsequently allowed to stabilize at room temperature for two days before being processed through electrospinning. The fabrication of the final composite membranes was performed according to protocols by NANOFABER S.r.l., by adding to Step 1 a second processing step of electrospray of a surface coating of AL-EU or AL-OA onto the PCL layer. The two steps were performed sequentially in situ using said industrial electrospinning equipment. Several coated membranes of 19 × 24 cm
2 in size were prepared for different sets of parameters, as listed in
Table 1.
2.3. Morphology, Mechanical Testing and Roughness of the Membranes
The morphological study of the membranes was conducted using a field emission gun scanning electron microscope (SEM) (Leo 1530, ZEISS, Jena, Germany) working at a low extraction voltage of 3.00 kV to avoid charging. Samples were analyzed without applying a conductive Au nanocoating. To measure the thickness of the membranes (Th), cross-sectional sections were placed between two silicon wafers. Three measurement points were taken for each cross-sectional section. In these measurements, a Zeiss AXIO Zoom.V16 microscope (ZEISS, Jena, Germany) was used, and images were processed using Zen Blue Version 3.4.91 software. In addition to image-based analysis, an experimental assessment of membrane porosity was conducted using the displacement volume technique using absolute ethanol.
The mechanical properties of the filter paper and of the PCL layers alone were evaluated by tensile tests, similarly to prior work [
15]. A macro-tensile loading frame (MICROTEST 200 N, DEBEN, Suffolk, UK) equipped with a 200 N load cell was used to test rectangular strips cut out of samples. The Young modulus (E) and the ultimate tensile strength (UTS) of each material were measured from their stress vs. strain curve, respectively, as the slope in the linear response region and as the maximum tensile stress reached before either the rupture or the onset of the softening phase.
The roughness value Ra (Arithmetic Average Roughness) for each sample was evaluated using NPS confocal scanning (NP1 probe, HIROX, Tokyo, Japan), a methodology compliant with ISO 21920 [
42].
2.4. Porosity and Permeability Determination
The porosity of the membranes was assessed using the liquid displacement method [
43,
44]. Ethanol (Merck, Darmstadt, Germany) was selected as a penetrating liquid due to its ability to infiltrate through the porous membrane, coupled with a lower density (ρ
EtOH ≅ 0.790 g/mL). The percent porosity (ε
%) was computed from Equation (1):
by determining the weights m1, m2, m3, and m4 on a scale (ORMA, BCA120, Milan, Italy) at a temperature of 20 °C. For a given membrane specimen, m1 represents the “as-dry” weight, m2 represents the weight of a “control” graduated bottle filled with ethanol up to a specified “control volume”, and m3 is the weight of the same bottle after the membrane specimen is inserted and immersed in the ethanol, with the displaced excess volume of ETOH carefully removed using a pipette to restore the control volume. Finally, m4 reflects the weight of the bottle containing the residual ethanol after the wet membrane is extracted.
The assessment of air permeability for the electrospun membranes was conducted using a Gurley densometer (model 4320, Troy, NY, USA). In this test, the time (
t) in seconds required for a volume (
V) of air equal to 100 cm
3 to pass through a surface (
A) with a fixed area of 1.58 cm
2 was measured. Equation (2) renders the permeability value (
P) for each sample in “cm/s” [
45].
2.5. Wettability Tests of Membranes
The wettability tests of the membranes were conducted by measuring the contact angle using a Leica Wild M3Z (part of Hexagon, Stockholm, Sweden) stereomicroscope. Images were captured using a Moticam 2000. For the contact angle analysis, two representative liquids were used: deionized water (WCA) to represent the hydrophilic part and “1PWD” (1 Primary Wound Dressing©) to represent the lipophilic part (OCA). The measurement of the contact angle between the membrane and a droplet of the liquid was performed 10 s after depositing 10 μL of the liquid onto the membrane surface.
2.6. ATR-FTIR Analysis
For the ATR-FTIR (Attenuated Total Reflection Fourier-Transform Infrared) analysis of the samples, a Nicolet iS50 spectrometer connected to the iD70 ATR accessory (Thermo Fisher Scientific, Waltham, MA, USA) was used. The crystal used for this ATR analysis was a monolithic diamond crystal. The spectra were recorded in absorbance mode with a resolution of 4 cm−1. Each sample was scanned 16 times in the wavelength range from 4000 to 400 cm−1.
2.7. Antimicrobial Test
Circular PCL disks with a diameter of 15 mm, created through the die-cutting process, were placed in 24-multiwell plates for Staphylococcus aureus (S. aureus) and Escherichia coli (E. coli) biological tests. S. aureus and E. coli stock cultures kept at −80 °C in 10% (w/v) glycerol (Merk Life Science S.r.l., Milan, Italy) were inoculated, respectively, into 3 mL of Nutrient broth (Biolife Italiana, Milan, Italy) and of Luria Bertani (LB) broth (Merck Life Science S.r.l., Milan, Italy). Both bacterial cultures were incubated at 37 °C O/N with constant shaking at 180 rpm before their use in experiments. The day of the test, the S. aureus bacterial concentration was diluted and grown until OD600 was 0.02, about 1.1 × 106 colony forming units/mL (CFU/mL); instead, the E. coli bacterial concentration was diluted and grown until OD600 was 0.028, about 5.0 × 106 colony forming units/mL (CFU/mL). Subsequently, the bacteria were introduced into a 24-well multiwell plate, where they were exposed to either uncoated PCL samples (blank disks) or Lignin-coated samples. The incubation took place at 37 °C under continuous agitation at 50 rpm. Two types of experiments were performed.
In the first experiment, a control with S. aureus alone was also inserted, and the samples were incubated with the microbial population. The survival rate was determined at 1.5 h and 3 h using the count plate method and the calculation of CFUs to determine the cytocitic action of the samples.
In the second experiment, at times t = 1 ½, 3, and 4.5 h, 10 μL of each sample were diluted in phosphate-buffered saline (PBS) (Euroclone, Milan, Italy) (serial dilution from 10−1 to 10−8) and 100 μL of each dilution were distributed on Nutrient agar dishes (15 g L−1 agar) (Panreac Química SLU, Barcelona, Spain) for S. aureus strain and on Luria Bertani agar (15 g L−1 agar) dishes for E. coli strain. All dishes were incubated for 18 h at 37 °C. Following the incubation period, colonies that had reached a size discernible bare-eye were enumerated, and the concentration corresponding to the counted colonies was determined.
The antibacterial experiments were replicated twice for consistency and reliability of the results. The acquired data were expressed as the mean ± SEM. Prism 7 software was utilized to perform Student’s t-test. Significant differences were highlighted for two significance levels as * p < 0.05 or ** p < 0.01.
4. Conclusions
We investigated and proved the feasibility of a two-step electrospinning fabrication of a biocompatible and biodegradable polymer-on-paper layered system made of electrospun PCL fibers subsequently coated with electrosprayed lignin, all in one production line. The manufacturing of pure lignin coatings by solution electrospraying appears to be novel. In our investigation, lignin was responsible for two main functional properties: (i) the increase in wettability of the substrate towards both polar and apolar liquids, displaying a characteristic amphiphilic effect; (ii) the newly acquired antibacterial properties over the bare PCL membrane. The results achieved with either AL-OA or AL-EU grade, for relatively small lignin densities of order 0.1 mg/cm2, indicate that those properties can be tuned with relative ease by the amount of deposited lignin, which makes for an interesting alternative to other surface processing options entailing chemical transformations or physical transformations (e.g., plasma treatments). Also, our data highlight that lignin coatings did not change the overall porosity (a bulk property) of the membrane but reduced surface roughness and moderately reduced air permeability as lignin density increased, which is crucial for filtration applications.
Although the current antibacterial effectiveness of these coated surfaces is significantly inferior to well-established alternatives, such as Ag coatings, there is unquestionably potential for enhancement in these initial endeavors. For instance, when considering the efficacy against Gram-positive and Gram-negative bacteria, i.e., S. aureus and E. coli, there is certainly room for improvement compared to established options like said Ag coatings. More importantly, the deployment of electrosprayed lignin coating is worth exploring and developing further due to its scalability and potential to be deployed industrially in high-throughput manufacturing of sustainable layered membranes with antibacterial and antifouling properties, not just in the field of filtration. Finally, by highlighting the difference between two acidolysis lignin grades, i.e., Quercus cerris L. (AL-OA) and Eucalyptus camaldulensis Dehnh (AL-EU) lignins, our study points out that better lignin grades can be in principle carefully selected and engineered upstream to optimize the subsequent electrospraying process. Thus, the capability to make pure lignin coatings by electrospraying opens up and supports the possibility of using and reusing this natural polymer, overabundant and available from wood byproducts, for filtration and for circular economy applications in general.